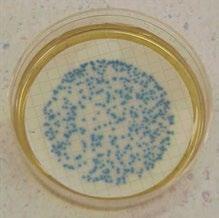

6 minute read
2019-2020 Appendix
Appendix A
Disease-Causing Microorganisms
Advertisement
Contaminated runoff and untreated sewage released into ocean and bay waters may result in swimmer exposure to pathogenic bacteria, viruses or protozoa. These disease-causing microorganisms may be present at or near the sites where discharges enter the water.
Disease-Causing Microorganisms
Pathogenic Agent Disease Bacteria
Escherichia coli (E. coli) Gastroenteritis
Salmonella (not typhi)
Gastroenteritis, usually with fever; less commonly septi¬cemia (generalized infection - organisms multiply in the bloodstream)
Some strains of Shigella Gastroenteritis, usually with fever
The following table lists the types of microorganisms and the diseases (or symptoms) they may cause.
Protozoa (Intestinal Parasites)
Cryptosporidium Diarrhea - Cryptosporidiosis Giardia lamblia Diarrhea - Giardiasis
Viruses
Rotavirus Gastroenteritis
Enteroviruses
Respiratory infection, rash, fever, meningitis
Norwalk and Norwalk-like viruses Gastroenteritis
Adenovirus
Hepatitis A (outbreaks associated with eating shellfish from sewage-contaminated water)
Respiratory infection and gastroenteritis
Infectious hepatitis (liver malfunction)
The levels of bacteria, viruses and protozoa typically decrease in ocean and bay waters over time due to the following reasons:
• Die-off due to sun (ultraviolet exposure), salt water or age.
• Predation by other organisms.
• Dispersion and dilution.
Indicator Bacteria Testing Methods
The detection and enumeration of disease-causing organisms (pathogens) identified with waterborne illness is difficult, time-consuming and costly. Thus, most water quality laboratories are required to test for fecal indicator bacteria (i.e., total coliforms, fecal coliforms and enterococci) as a means to ascertain the likelihood that human pathogens may be present in recreational waters. Fecal indicator bacteria normally occur in the intestines of all warm-blooded animals, are excreted in high numbers in feces, but can also be found in soil and decaying vegetation. Since there is no ideal indicator group, testing is done for more than one indicator. Total coliforms are a broad group of organisms that include fecal coliform bacteria as well as E. coli. The enterococci group has been determined to be a good indicator of water-contact associated gastroenteritis. The methods most commonly used to detect fecal indicator bacteria in water include:
Membrane Filtration (MF)
Multiple-Tube Fermentation (MTF)
Colilert®
Enterolert® culture medium designed to encourage the growth of the target indicator. The filter is incubated for 22–24 hours to allow the bacterial cells to multiply into visible colonies. Theoretically, each bacterial cell (or clump of cells) produces a single colony on the membrane.
All of the methods are culture based, which means that the indicator bacteria present in water must be allowed to grow in order to be detected. Differences between the methods include how the bacteria are detected and counted, how soon the results become known and cost. Each method has its advantages and disadvantages. Most of the limitations depend on factors such as the other types of constituents in the water and density of bacteria present, and all require at least an 18hour incubation period. The following is a brief summary of the Membrane Filtration method, the method used by the HCA/Public Health Laboratory, the South Orange County Wastewater Authority Laboratory, and the Orange County Sanitation District Laboratory for the analyses of total coliforms, fecal coliforms, and enterococci in ocean and bay waters. Detailed descriptions for the Membrane Filtration (MF), Multiple-Tube Fermentation (MTF), Colilert® and Enterolert® methods are available in the latest edition of Standard Methods for the Examination of Water and Wastewater.
The colonies are viewed under a 10X magnifying lens and distinguished from non-target bacteria based on the type, size and color of the colonies. Target bacteria are indicated by pigment production resulting from bacterial enzymatic reactions to specific substrates. The number of colonies present in 100 milliliters of water, also known as
“Colony Forming Units” (CFUs), is counted and the concentration of organisms in the original sample is calculated.
Total Coliform Colonies
Fecal Coliform Colonies
Membrane Filtration (MF)
The Membrane Filtration method involves filtering water through a porous membrane to concentrate or trap bacteria from the water sample on the filter surface. The membrane filter is placed onto a
Enterococcus Colonies


Ocean Water-Contact Sports Standards – Assembly Bill 411 (AB 411)
In 1998, AB 411 (Wayne) was chaptered into law and added Sections 115875115915 to the California Health and Safety Code. The law authorized the creation of bacteriological ocean water quality standards that are considered protective of public health (California Code of Regulations Sections 7956-7962).

The standards are informally called “AB 411 Standards” and include the following:
Required testing of the waters adjacent to all ocean and bay public beaches for total coliforms, fecal coliforms and enterococci bacteria that may indicate the presence of possible disease-causing bacteria, viruses or protozoa.
Required maintenance and updates of the Ocean, Harbor and Bay Posting and Closure Hotline.
Established single sample standards for total coliforms, fecal coliforms and enterococci bacteria which shall not exceed:
6 Total Coliforms: 10,000 organisms per 100 milliliter sample.
6 Fecal Coliforms: 400 organisms per 100 milliliter sample.
6 Enterococci: 104 organisms per 100 milliliter sample.
6 Fecal Coliform to Total Coliform ratio: >1,000 total coliforms if ratio exceeds 0.1.
Established 30-day geometric mean standards (of five weekly samples) for total coliforms, fecal coliforms and enterococci bacteria which shall not exceed:
6 Total Coliforms: 1,000 organisms per 100 milliliter sample.
6 Fecal Coliforms: 200 organisms per 100 milliliter sample.
6 Enterococci: 35 organisms per 100 milliliter sample.
When any waters adjacent to a public beach fail to meet any of the standards described above, the local health officer shall post signs on the beach to restrict access to the affected waters.
Weekly testing is required from April 1 – October 31 if the following apply:
6 The beach is visited by more than 50,000 people annually.
6 The beach is located in an area adjacent to a storm drain that flows in the summer.
In the case of a known release of sewage into ocean or bay waters adjacent to a public beach, the local health officer is required to:
6 Immediately close the affected ocean or bay waters until the source of the sewage is eliminated.
6 Collect bacterial samples from the affected waters.
6 Continue the closure until testing results of water samples meet the established standards.
Public Notification and Risk Communication
Public notification and risk communication are a critical component of the WQ Team. Public awareness and enhancing the capacity for informed personal choice are important factors in ensuring public health protections are provided to recreational water users. The WQ Team has established and maintains an integrated management system to inform the public of the potential health risks associated with water contact activities in coastal recreational waters that do not meet applicable water quality standards. Multiple communication measures are promptly taken to notify the public when ocean, harbor or bay water areas do not meet or are expected not to meet AB 411 Ocean Water-Contact Sports Standards. The WQ Team implements the following types of public notification measures to communicate information regarding beach water quality and to protect the health of beach users:
Email Hotline – The Email Hotline is the digital written version of the information that is provided on the Telephone Hotline that is sent out when changes occur to a list serve of stakeholders and the public.
Social Media – Public notification of ocean water quality status changes are being communicated to the public through the social media network of Twitter. For the latest information and instant ocean water quality updates when they occur, follow us on Twitter at http://twitter.com/ochealth
Press Releases – Public notification of a beach closure or rain advisory is provided in a press release issued by the HCA. The press release will indicate whether a closure or advisory is being issued, the reason for the closure or advisory, the area affected and the anticipated duration of the closure or advisory.
Beach Signs – Signs are posted to notify beach users of the current status of the ocean, harbor or bay water area. Posted beach signs are located where they are most likely to be noticed by beach users and provide a visual notice at the point of ocean water access.
Telephone Hotline – The Ocean, Harbor and Bay Water Closure & Posting Telephone Hotline has been established to inform the public about all beaches that are currently closed, posted with a health warning or when a rain advisory has been issued. The telephone hotline message is immediately updated when a change in the status of beach closures, postings or advisories occurs. The Ocean, Harbor and Bay Water Closure & Posting Telephone Hotline is (714) 433-6400
Annual Reports – To assess the health of the ocean, harbor and bay waters being monitored, the WQ Team compiles a report of the beach closures, postings and advisories after the year has ended. The annual or biennial Ocean, Harbor and Bay Water Quality Report provides an updated analysis of bacteriological water quality, describes year-to-year variability and trends for Orange County’s recreational waters, and includes data on sewage spills and beach closures. Reports from 2002 to present can be viewed and downloaded from the Ocean, Harbor and Bay Water Closure & Posting Web Page at www.ocbeachinfo.com.
